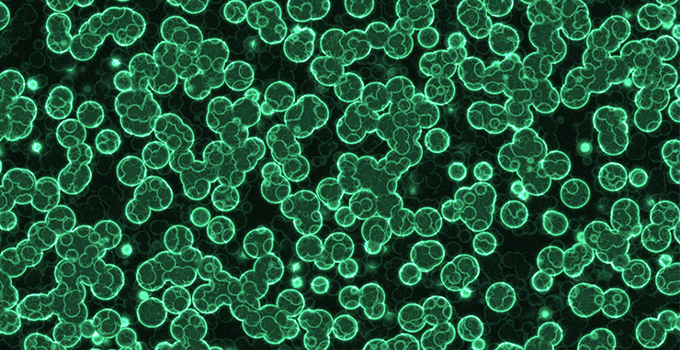

Canlılar Ölüyor! Ne Yapmalıyım? Veya Ne Yapmadın?

Akvaryumda canlılar ölüyorsa bunun bir çok nedeni olabilir. Böyle bir durumda, bu soruya karşı verilen en yaygın öneri su değişimi yapılmasıdır. Ancak su değişimleri bunun için bir çözüm değildir ve buradaki sorun ne yapılması gerektiği değil ne yapılmadığıdır. Aslında bu sorunun tamamen yanlış olduğunu söyleyebilirim. Doğru soru ”Ne yapmalıyım?” yerine kendinize soracağınız ”Ne yapmadım?” olmalıdır. […]
Mercan Beyazlaması Nedenleri ve Çözümleri

ilk kez 1990’larda Güney Pasifik’teki mercan resiflerinde görüldükten sonra dikkat çekmeye başladı. Mercan Beyazlaması akvaryumlarımızda da meydana geliyor.
Baloncuk Yosunu (Bubble Algae) Küçük Yeşil Adamlar!

Evet uzaylılar gerçek ve şimdi küçük yeşil adamlar akvaryumunuzu istila ediyor! Baloncuk yosunu tuzlu su akvaryumları için süprizlerin en kötüsüdür. Doğru koşullarda, hızla çoğalır ve yayılırlar. Bir çok otobura karşı iyi direnç gösterirler ve mercanlarınızın boğulma tehlikesiyle karşı karşıya kalmalarına neden olurlar. Baloncuk Yosunu (Bubble Algae) Nedir? Baloncuk yosunu veya ”Denizcinin Göz Küresi” olarak da […]
Akvaryumların Kabusu Bryopsis Yosunu

Neredeyse hiç bir doğal düşmanlarının olmayışı ve hızlı yayılmaları Bryopsis yosunu nu zorlu bir rakip haline getiriyor. Ama onlardan kurtulablirsiniz.
Montipora Katili Nudibranchs Zararlısı

Montipora katili Nudibranchs, mercanla beslendiği bilinen bir tür aeolid nudibranch türüdür. Bu parazitleri akvaryumumuzdan uzak tutmak önemlidir. Nudibranch’lar, Montipora ve Anacropora cinsinden mercan dokuları ile beslenir. Bu nudibranch’lar çok kısa sürede çok miktarda mercanı yok edebilir. Şaşırtıcı bir şekilde çoğaldıkları için, hızlı bir şekilde hasar verebilirler. Nudibranch’ları, üreme ve yeme oranları nedeniyle kontrol altına almak zordur. Beyaz ve […]
Siyanobakteri Ve Kurtulma Yolları
Siyanobakteri, tuzlu su akvaryumlarında karşılaşılan en yaygın sorunlardan biridir. Şimdi sizlere onlardan nasıl kurtulacağınızdan bahsedelim.
Asterina Deniz Yıldızı

Asterina deniz yıldızı tamamen zararlı mı yada tamamen zararsız mı tartışmalı bir konudur. Mercanlarınıza zarar vermeden akvaryumunuzda yaşayabilir yada tam tersi olabilir, ama hangisi zararlı hangisi zararsız ilk bakışta anlamak zordur. Bazı Asterina yıldızlarının kesinlikle mercan biçici olarak doğduğunu söyleyebiliriz. Yine de büyük Asterina yıldızı türlerinin olgun bir tuzlu su akvaryumu popülasyonunun masum bir üyesi olduğuda […]
